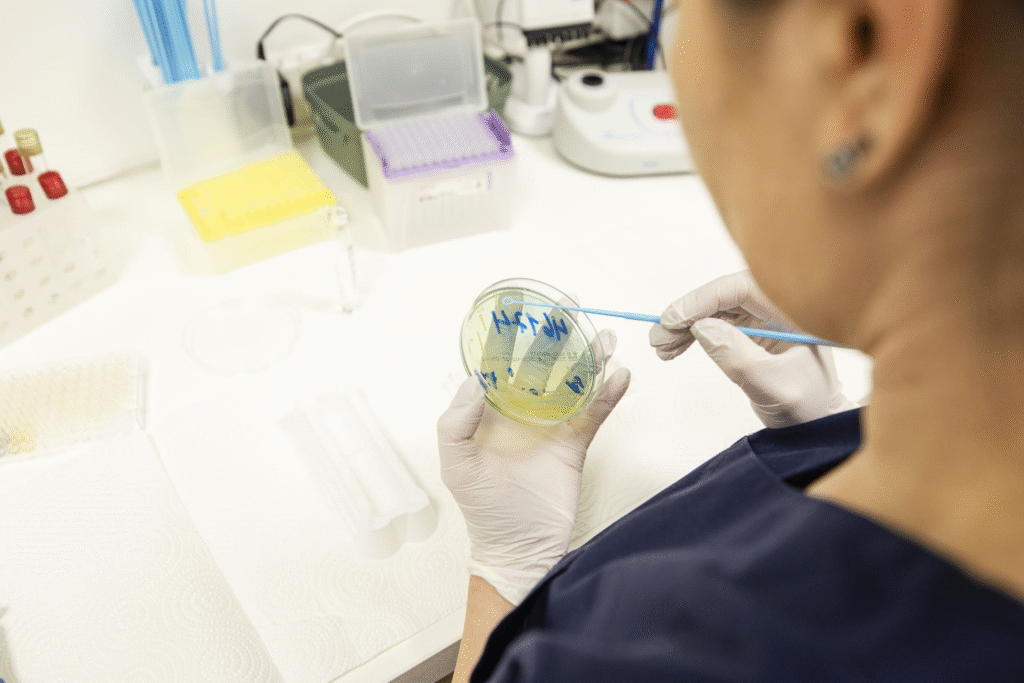

Das Team
In unserer modern ausgestatteten und vollständig digitalisierten urologischen Praxis bieten wir Ihnen das gesamte Spektrum der Urologie – kompetent, individuell und auf dem neuesten Stand der Medizin.
Das Praxisteam

PD Dr. Nils Kröger
Facharzt für Urologie, Fellow of the European Board of Urology (F.E.B.U), Medikamentöse Tumortherapie, Onkologisch verantwortlicher Arzt, Lehrbeauftragter der Universitätsmedizin Greifswald

Dr. Michael-Jan Schuhmann
Mareike Drange
Praxismanagement
Gesundheitsmanagement Master of Arts M.A.
Marie Hahn
Stellvertretende klinische Praxismanagerin
verantwortlich für Studien/Dokumentationsassistenz
Empfang
Christin Schmidt
Leitende MFA
verantwortlich für OP, Hygiene und Onkologie
Sandra Tieck
Stellvertretende MFA
verantwortlich für Labor und Mikrobiologie
Thi Kim Phuong Trinh
MFA
Jule Koch
MFA
Richard Reiche
MFA
Gesundheits- und Krankenpfleger
Akademische Laufbahn
Vorstellung PD Dr. Kröger

-
03/2016
Habilitation und venia legend mit der Arbeit „Personalized Clinical Management of Renal Cell Carcinoma Patients: Definition of Clinical, Molecular, and Genetic Prognostic Features”
-
12/2007
Promotion mit einer experimentellen Arbeit zum Thema: „Entwicklung eines plastischen Trägers für die Autologe-Chondrozyten-Transplantation: Ein In-vitro-Modell“; Bewertung: summa cum laude
-
10/2001 – 12/2007
Studium der Humanmedizin an der Friedrich-Schiller-Universität Jena
Berufliche Laufbahn

-
Seit 07/2019
Facharzt für Urologie in eigener Niederlassung, Magdeburg
-
11/2018 - 06/2019
Facharzt für Urologie in der Praxis für Urologie Dr Klatte, Magdeburg
-
04/2017 – 10/2018
Oberarzt, Universitätsmedizin Greifswald, Klinik und Poliklinik für Urologie, Leiter Sektion Onkologie und Urologische Poliklinik
-
03/2015 -03/2017
Facharzt, Universitätsmedizin Greifswald, Klinik und Poliklinik für Urologie
-
11/2011 – 03/2015
Assistenzarzt, Universitätsmedizin Greifswald, Klinik und Poli-klinik für Urologie
-
03/2015 – 02/2016
Domagk Stipendiat am Institut für Medizinische Biochemie an der Universitätsmedizin Greifswald
-
09/2012 – 02/2013
Clinical and Research Fellowship am Tom Baker Cancer Centre, Medical Oncology, University of Calgary, Canada
-
09/2010 – 09/2011
Research Fellowship Institute for Urologic Oncology David Geffen School of Medicine University of California, Los Angeles, USA
-
02/2008 – 09/2010
Assistenzarzt, Klinik und Poliklinik für Urologie, Universitätsklinikum Jena
Berufliche Laufbahn
Vorstellung Dr. Schuhmann

-
Seit 07/2022
Praxis für Urologie im NVZ am Altmarkklinikum Gardelegen
-
07/2019 – 06/2022
Medizinischer Dienst Sachsen-Anhalt, Referatsleiter für Methoden und Arzneimittelbegutachtung. WB Sozialmedizin
-
09/2015 – 06/2019
Wechsel an das ELBE-MVZ Magdeburg als ärztlicher Leiter und ambulant tätiger Facharzt für Urologie an der urologischen Klinik des St. Marienstift Magdeburg
-
01/2013 – 08/2015
Wechsel aus der selbstständigen in die angestellte Tätigkeit als klinischer Oberarzt des Altmarkklinikum Salzwedel und ambulant tätiger Facharzt im "Fachärztlichen Zentrum am Altmarkklinikum"
-
03/07/2008
Prüfung zur Zusatzbezeichnung Medikamentöse Tumortherapie
-
27/11/2007
Prüfung zur Zusatzbezeichnung Andrologie
-
01/01/2002
Niederlassung in der Gemeinschaftspraxis Salzwedel
-
09/10/2001
Prüfung zur Gebietsbezeichnung Facharzt für Urologie
-
04/1999 – 12/2001
Tätigkeit als Assistenzarzt/Facharzt der urologischen Abteilung des Ohreklinikum Haldensleben
-
04/1998 – 03/1999
Tätigkeit als Assistenzarzt der Chirurgischen Abteilung des Ohreklinikum Haldensleben
-
04/1997 – 03/1998
Tätigkeit als Assistenzarzt an der Urologischen Universitätsklinik Magdeburg
-
10/1995 – 03/1997
Tätigkeit als Arzt im Praktikum an der Urologischen Universitätsklinik Magdeburg
-
09/1994 – 09/1995
Praktisches Jahr an der medizinischen Fakultät de Otto-von-Guericke Universität Magdeburg, in den Fächern innere Medizin und Chirurgie
-
09/1989 – 09/1994
Studium der Humanmedizin an der medizinischen Fakultät der Otto-von-Guericke Universität
06/1991 Physikum
06/1992 1. Teil der ärztlichen Prüfung
06/1994 2. Teil der ärztlichen Prüfung
Wissenschaftliche Tätigkeiten

-
27/06/2001
Doktorgrad verliehen durch die Otto-von-Guericke Universität Magdeburg
-
Promotionsarbeit zum Thema: "Veränderungen im praktischen Umgang des ambulant tätigen Urologen mit Prostatakarzinompatienten im Verlauf der letzten 20 Jahre - eine retrospektive Analyse von 364 dokumentierten Behandlungsverläufen"
-
Eingereicht J. Urol. 09/09/1998
Case Report: Ulcerative Balanoposthitis - first manifestation of acute promyeloic leukemia
-
1997
Untersuchungen zu Fragen der zellulären Adhäsion un dEntzündung bei der lokalisierten Metastasierung des Nierenzellkarzinoms (Institut für Medizinische Mikrobiologie, Prof. Dr. med. W. König)
-
1975 – 1985
Follow-up Studie: "Schicksal der kontralateralen Niere nach unilateraler Tumornephrektomie beim Nierenzellkarzinom", 140 Patienten. Vorgetragen DGU Wiesbaden 26/09/1997
